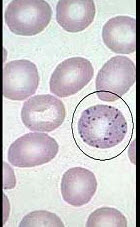
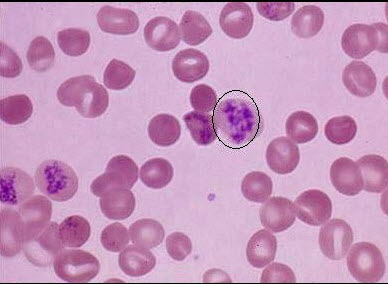
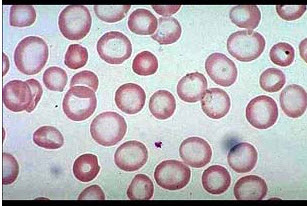
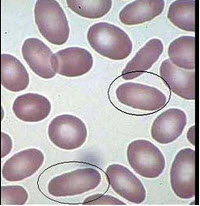
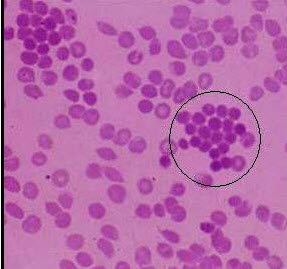
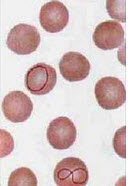
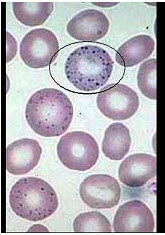

时间:2024-03-06 03:13:07


1、填空题 急性再障起病急,进展迅速,病程短,此型再障又称为________;慢性再障起病缓慢,病程进展慢较平稳,如病情恶化,转为重型再障,称为_________。
2、单项选择题 下列哪种疾病可见总铁结合力升高()
A.肾病综合征
B.肝硬化
C.缺铁性贫血
D.恶牲肿瘤
E.先天性转铁蛋白缺乏
3、问答题
患者,男,17岁,因面色苍白12天入院。体格检查:体温37℃,脉搏94次/分,呼吸16次/分。血压14/9kPa,中度贫血貌,肝脾大。皮肤粘膜轻度黄染。实验室检查:Hb90g/L。WBC7.6×109/L,RBC3.58×1012/L,MCV74fl,MCH24pg,MCHC0.32,网织红细胞0.06,血清总胆红素47.1μmol/L;骨髓增生明显活跃,以红系增生为主。血红蛋白电泳:HbE94%,HbF6%,HbA消失。试分析该病例。
4、单项选择题
患者,女,31岁,2年前无明显诱因出现巩膜发黄,全身乏力,常感头昏,皮肤瘙痒,并多次出现酱油色尿。近两个月来,乏力加重,无法正常工作而入院治疗。体格检查:中度贫血貌,巩膜黄染,肝肋下2cm,脾平脐,其余未见异常。血常规:WBC9.2×10/L,Hb42g/L,RBC1.08×10/L,PLT109×10/L。外周血可见晚幼红细胞及晚幼粒细胞,成熟红细胞明显大小不等和形态异常,可见较多的小球形红细胞和嗜多色性红细胞,网织红细胞32%。拟诊“溶血性贫血”入院。
为确定溶血原因,应首选下列哪些实验室检查()
A.血浆游离血红蛋白测定和红细胞寿命测定
B.体液免疫和细胞免疫
C.肝功能和肾功能检测
D.Coombs试验、酸溶血试验及寻找原发病存在的试验
E.骨髓检查
5、单项选择题
男性,16岁,面色苍白半年。体检:中度贫血貌,巩膜轻度黄染,脾肋下2.5cm。检验:血红蛋白81g/L,白细胞及血小板正常,网织红细胞16%;Coombs试验(-);红细胞渗透脆性试验,初溶为58%氯化钠溶液,全溶为46%氯化钠溶液。
患者可能为哪种溶血性贫血()
A.G-6-PD缺乏症
B.高铁血红蛋白血症
C.珠蛋白生成障碍性贫血
D.PNH
E.遗传性球形红细胞增多症
6、单项选择题 全血细胞减少最常见于()
A.缺铁性贫血
B.溶血性贫血
C.再生障碍性贫血
D.白血病
E.巨幼红细胞性贫血
7、多项选择题 下述符合溶血性贫血的是()
A.网织红细胞数目增加
B.血片可见幼稚红细胞
C.骨髓增生明显活跃
D.红细胞寿命缩短
E.以上都是
8、单项选择题 按贫血的形态学分类,骨髓病性贫血属下列哪项()
A.单纯小细胞性贫血
B.小细胞低色素性贫血
C.正常细胞性贫血
D.大细胞性贫血
E.珠蛋白生成障碍性贫血
9、单项选择题 因功能需要红细胞膜收缩蛋白α链和β链可相互扭合聚集成SPT,SPT是指()
A.收缩蛋白二聚体
B.收缩蛋白三聚体
C.收缩蛋白四聚体
D.收缩蛋白五聚体
E.收缩蛋白六聚体
10、问答题 叶酸缺乏的巨幼细胞性贫血的诊断标准是什么?
11、多项选择题
如图所示的异常红细胞可见于哪些疾病()
A.再障
B.巨幼细胞贫血
C.骨髓纤维化
D.铅中毒
E.缺铁性贫血
12、名词解释 单纯红细胞系再生障碍
13、问答题 红细胞在体内的衰亡和破坏的场所如何?
14、判断题 HbA比HbF有更强的抗碱作用。()
15、单项选择题 胎儿水肿综合征与下列哪种血红蛋白有关()
A.HbS
B.HbH
C.HbE
D.HbF
E.HbBarts
16、单项选择题
男性,13岁,反复发热,深黄色尿2年。体检:巩膜轻度黄染,脾肋下2.5cm。检验:血红蛋白90g/L。网织红细胞12%;血涂片显示红细胞呈小球形,中央苍白区消失;尿胆红素阴性,尿胆原强阳性。
患者可能为下列哪种疾病()
A.肝炎
B.缺铁性贫血
C.铁粒幼细胞贫血
D.再生障碍性贫血
E.溶血性贫血
17、问答题 G-6-PD酶缺乏症的筛选和确诊是试验可有哪些?
18、单项选择题
某患者自幼贫血,脾肿大。外周血涂片如图1,骨髓涂片如图2,该患者可能为()
A.缺铁性贫血
B.地中海贫血
C.巨幼细胞贫血
D.再障
E.HbS病
19、多项选择题 急性再障与慢性再障相比有哪些特点()
A.前者网织红细胞较高
B.前者血红蛋白下降较快
C.前者白细胞数更低
D.前者中性粒细胞较高
E.前者血小板更低
20、判断题 含铁血黄素是一种脂溶性的铁蛋白。()
21、单项选择题
某患者贫血、脾肿大。如图,若外周血圈中所示红细胞占19%,最可能为()
A.缺铁性贫血
B.巨幼细胞性贫血
C.再生障碍性贫血
D.先天性球形红细胞增多症
E.失血性贫血
22、单项选择题 阵发性睡眠性血红蛋白尿时,下列哪项实验常呈阳性()
A.红细胞渗透脆性试验
B.抗人球蛋白试验
C.异丙醇实验
D.冷凝集素试验
E.尿含铁血黄素试验
23、多项选择题 下列哪些指标支持小细胞低色素性贫血的诊断()
A.MCV65fl
B.MCV88fl
C.MCH22pg
D.MCH31pg
E.MCHC0.28
24、单项选择题 缺铁性贫血与铁粒幼细胞性贫血的鉴别要点是()
A.血清铁
B.血清总铁结合力
C.骨髓铁染色
D.红细胞内游离原卟啉测定
E.MCV、MCH、MCHC测定
25、名词解释 蚕豆病
26、填空题 红细胞增多症是指____、____和____异常增高,超过_____。可分为____和____两类。
27、单项选择题
贫血患者血片如图,运铁蛋白饱和度0.12,最可能的诊断是()
A.再生障碍性贫血
B.缺铁性贫血
C.慢性感染性贫血
D.铁粒幼细胞性贫血
E.自身免疫性溶血性贫血
28、单项选择题 下列说法哪项不符合先天性球形红细胞增多症()
A.红细胞渗透脆性增高
B.外周血球形红细胞大于20%
C.脾肿大明显
D.自身溶血试验明显增高,加葡萄糖不能纠正
E.属于先天性红细胞膜异常性疾病
29、判断题 蜂毒不能直接破坏红细胞膜。()
30、问答题 何为小细胞性贫血?哪些贫血属小细胞性贫血?
31、问答题 简述我国现行再障的诊断标准。
32、单项选择题 下列哪种溶血性贫血是获得性红细胞膜缺陷所致()
A.原发性睡眠性血红蛋白尿症
B.遗传性椭圆形红细胞增多症
C.遗传性球形红细胞增多症阵
D.自身免疫性溶血性贫血
E.微血管病性溶血性贫血
33、判断题 大细胞性贫血首选网织红细胞检查。()
34、单项选择题
某女,长期月经过多,血片如图,为进一步明确诊断,需进行下列何种检查()
A.维生素B12测定
B.Ham试验
C.铁代谢检查
D.Coombs试验
E.Hb电泳检测
35、单项选择题
如图,若外周血圈中所示红细胞增多,最常见于()
A.白血病
B.缺铁性贫血
C.溶血性贫血
D.骨髓病性贫血
E.再生障碍性贫血
36、填空题 小细胞低色素性贫血时MCV____,MCH____,MCHC____;大细胞性贫血时MCV____,MCH____,MCHC____;单纯小细胞性贫血时MCV____,MCH____,MCHC____。
37、单项选择题 铁在消化道的吸收部位主要是()
A.胃
B.肝
C.回肠
D.结肠
E.十二指肠和空肠上段肠粘膜
38、单项选择题
男性,57岁,近半个月厌食、恶心、头晕、乏力伴皮肤黄染。检验:血红蛋白80g/L,网织红细胞5%;红细胞脆性试验轻度增加;尿胆红素阴性,尿胆原强阳性,尿潜血检查阴性,血清总胆红素77.25μmol/L,ALT28U/L。拟诊为溶血性贫血。
若上述试验阴性,结合其他检查,该患者最可能为()
A.遗传性球形红细胞增多症
B.新生儿溶血症
C.异常血红蛋白病
D.免疫性溶血性贫血
E.珠蛋白生成障碍性贫血
39、单项选择题 HbBarts的组成是()
A.γ4
B.δ4
C.α2β2
D.α2γ2
E.α2δ2
40、单项选择题
女性,32岁,肝、脾肿大,血红蛋白69g/L,网织红细胞15%,白细胞、血小板正常,骨髓红细胞系统增生明显活跃,Coombs试验阴性;Ham试验阴性,红细胞渗透脆性试验正常;自溶试验增强,加葡萄糖不纠正,加ATP纠正,疑为遗传性溶血性贫血。
最可能诊断为()
A.遗传性球形红细胞增多症
B.珠蛋白生成障碍性贫血
C.G-6-PD缺乏症
D.不稳定血红蛋白病
E.PK酶缺乏症
41、判断题 贫血的诊断以查明贫血的性质和病因最为重要。()
42、问答题 何谓溶血性贫血,试述确定溶血存在的依据及其变化情况。
43、单项选择题 成人中度贫血血红蛋白含量为()
A.31~60g/L
B.60~90g/L
C.80~100g/L
D.60~120g/L
E.100~120g/L
44、配伍题 可能有血管内溶血()提示红细胞代偿性增生()可能为自身免疫性溶血()可能为PNH()
A.Coombs试验阳性
B.Ham试验阳性
C.血清间接胆红素阳性,尿胆原,粪胆原增加
D.网织红细胞增多
E.尿含铁血黄素阳性
45、问答题 哪些因素可影响红细胞膜的稳定?
46、名词解释 珠蛋白生成障碍性贫血
47、单项选择题 血清结合珠蛋白参考值为()
A.0.5~1.5g/L
B.2.0~3.5g/L
C.3.0~4.5g/L
D.4.6~6.0g/L
E.6.1~7.5g/L
48、名词解释 原位溶血
49、问答题 溶血性贫血按病因学如何分类?
50、多项选择题 未衰老的红细胞过早破坏可能与下列哪些机制有关()
A.脾功能亢进
B.红细胞内血红蛋白减少
C.红细胞内血红蛋白聚集或沉淀
D.红细胞内酶异常
E.红细胞膜附着有不完全抗体或补体
51、多项选择题
如图所示的异常红细胞结构为()

A.嗜碱性点彩红细胞
B.H-J小体
C.网织红细胞
D.疟原虫
E.卡波环
52、填空题 镰状细胞贫血的病变为_____链第6位____被____替代形成_____。
53、多项选择题 血管内溶血的特征不包括()
A.清结合珠蛋白升高
B.尿胆原升高
C.血清游离血红蛋白明显升高
D.间接胆红素明显升高
E.高铁血红素白蛋白复合物出现
54、配伍题 铁粒幼细胞性贫血()巨幼细胞贫血()缺铁性贫血贮铁缺乏期()缺铁性贫血红细胞生成期()缺铁性贫血期()
A.内因子缺乏
B.铁粒幼红细胞增多
C.贮存铁下降,早期出现血清铁蛋白下降
D.贮存铁更进一步减少,铁蛋白减少,血清铁和转铁蛋白饱和度下降,总铁结合力增高和游离原卟啉升高,出现一般症状
E.除上述特点外,尚有明显红细胞和血红蛋白减少,并出现多个系统症状
55、单项选择题 下列哪项不属于血红蛋白病()
A.卟啉病
B.高铁血红蛋白血症
C.镰状细胞贫血
D.血红蛋白E病
E.β地中海贫血
56、单项选择题 酸洗脱法检测HbF检查,2周岁后参考值为()
A.<15%
B.<4.5%
C.10%
D.<2.0%
E.<16%
57、单项选择题 下列哪项疾病是获得性溶血性贫血()
A.丙酮酸激酶缺陷症
B.冷凝集素综合征
C.镰状细胞贫血
D.遗传性球形红细胞增多症
E.不稳定血红蛋白病
58、问答题 影响铁吸收的因素。
59、名词解释 G-G-PD缺陷症
60、多项选择题
如图为某患者骨髓铁染色结果。下列说法正确的是()

A.圈中所示为环形铁粒幼红细胞
B.细胞内铁是指存在于中幼红细胞、晚幼红细胞及成熟红细胞中的铁
C.细胞外铁主要存在于骨髓小粒的巨噬细胞中
D.铁粒幼细胞贫血中环形铁粒幼红细胞占20%以上
E.MDS患者也可见环形铁粒幼红细胞
61、单项选择题 成人主要血红蛋白(HbA)由哪几条肽链组成()
A.两条α和两条β肽链
B.两条α和两条δ肽链
C.两条α和两条γ肽链
D.两条β和两条γ肽链
E.两条β和两条δ肽链
62、问答题 巨幼细胞性贫血应与哪些疾病相鉴别?
63、单项选择题 下列哪项属于增生性贫血()
A.缺铁性贫血
B.再生障碍性贫血
C.MDS
D.慢性疾病性贫血
E.巨幼红细胞性贫血
64、单项选择题 红细胞镰变试验用于诊断下列哪种疾病()
A.HbC病
B.HbE病
C.HbH病
D.HbS病
E.HbBarts病
65、多项选择题 用于红细胞生成减少所致贫血的检查有()
A.高铁血红蛋白还原试验
B.血清铁检测
C.血清铁蛋白测定
D.血浆维生素B12检测
E.红细胞G-6-PD活性测定
66、单项选择题 继发性再障可能与下列哪些因素有关()
A.红细胞缺乏
B.中性粒细胞缺乏
C.单核细胞缺乏
D.维生素缺乏
E.有毒的化学物质如苯
67、填空题 再障患者的血象中通常网织红细胞绝对值______,中性粒细胞_____,淋巴细胞比例_____,血小板_____。
68、单项选择题
男性,16岁,面色苍白半年。体检:中度贫血貌,巩膜轻度黄染,脾肋下2.5cm。检验:血红蛋白81g/L,白细胞及血小板正常,网织红细胞16%;Coombs试验(-);红细胞渗透脆性试验,初溶为58%氯化钠溶液,全溶为46%氯化钠溶液。
本例贫血发病机制可能为()
A.遗传性红细胞膜缺陷
B.获得性红细胞膜缺陷
C.红细胞磷酸己糖旁路中的酶缺陷
D.珠蛋白肽链合成减少
E.红细胞自身抗体产生
69、单项选择题 高铁血红蛋白还原试验正常人还原率为()
A.10%
B.25%
C.45%
D.60%
E.75%以上
70、填空题 血红蛋白Barts病,又称_____,是由于缺失4个_______,无___生成,正常______缺乏,而____自行聚合形成______。
71、多项选择题 增生性贫血包括()
A.再生障碍性贫血
B.溶血性贫血
C.血红蛋白病
D.失血性贫血
E.缺铁性贫血
72、填空题 再障危象要与两种疾病鉴别诊断:_______________、__________________________。
73、多项选择题
如图,圈中所示红细胞绝对值减少见于下列哪些疾病()
A.巨幼细胞贫血
B.遗传性球形红细胞增多症
C.缺铁性贫血
D.再障
E.PNH
74、多项选择题 下列描述哪些组合是正确()
A.失血性贫血——正常细胞正色素性贫血
B.溶血性贫血——正常细胞正色素性贫血
C.缺铁性贫血——小细胞低色素性贫血
D.再生障碍性贫血——小细胞低色素性贫血
E.巨幼细胞性贫血——可见红细胞大小不均
75、多项选择题 下列哪些说法符合巨幼细胞性贫血()
A.可有牛肉舌的临床表现
B.大细胞正色素性贫血
C.粒、红、巨核系细胞均出现巨幼变
D.多起源于营养不良
E.中性粒细胞核右移
76、单项选择题
如图,若圈中所示红细胞为12%,可排除哪种贫血()

A.不稳定血红蛋白病
B.再生障碍性贫血
C.遗传性球形红细胞增多症
D.G-6-PD酶缺乏症
E.海洋性贫血
77、问答题 根据病因和发病机制简述贫血的分类。
78、单项选择题
男性,36岁,头晕乏力1年余,近1个月加重伴皮肤黄染。检验:血红蛋白50g/L,白细胞3.0×109/L,血小板48×109/L,网织红细胞20%;尿胆红素(-),尿胆原(+),尿含铁血黄素(+),血清铁蛋白12μg/L;骨髓检查示增生活跃,红系占53%,以中幼、晚幼红细胞增生为主。
本病例最可能诊断为()
A.缺铁性贫血
B.珠蛋白生成障碍性贫血
C.自身免疫性溶血性贫血
D.PK酶缺乏症
E.PNH
79、填空题 显示溶血的实验室检验主要有____、____、____、_____、_____。
80、多项选择题 铁粒幼细胞贫血的特征()
A.骨髓红系增生
B.细胞内外铁明显增多
C.高铁血症
D.正色素性贫血
E.大量环形铁粒幼红细胞
81、单项选择题 外周血中不出现有核红细胞的疾病是()
A.溶血性贫血
B.骨髓纤维化
C.缺铁性贫血
D.红白血病
E.恶性肿瘤骨髓转移
82、单项选择题 缺铁性贫血的细胞形态学表现为()
A.小细胞低色素性贫血
B.小细胞正色素性贫血
C.正细胞正色素性贫血
D.大细胞低色素性贫血
E.大细胞性贫血
83、单项选择题 缺铁性贫血红细胞MCV及RDW的变化是()
A.RDW正常,MCV降低
B.RDW升高,MCV降低
C.RDW正常,MCV正常
D.RDW正常,MCV升高
E.RDW升高,MCV升高
84、单项选择题 下列哪种疾病不属于遗传性疾病()
A.PNH
B.G-6-PD缺陷症
C.PK酶缺陷症
D.珠蛋白生成障碍贫血
E.血友病
85、多项选择题 下列哪些试验有助于PNH的确诊()
A.尿含铁血黄素试验
B.蔗糖溶血试验
C.酸溶血试验
D.蛇毒因子溶血试验
E.红细胞渗透脆性试验
86、问答题
患者,男,19岁,1年前明显出现疲乏无力,伴头晕,活动性心悸,曾入院治疗,但诊治不详,近期再次出现以上症状,面色苍白,无发热,无皮肤出血点,其他体格检查正常。实验室检查:RBC2.8×1012/L,Hb62g/L,MCV74fl,MCH22pg,MCHC0.30,PLT120×109/L,网织红细胞0.012。尿常规正常,肝、肾功能正常;血涂片如图。骨髓象:有核细胞增生活跃,红系增生明显,中幼红细胞占27%,晚幼红细胞占30%,各期红细胞体积均较小,胞核小而致密,胞浆少,边缘不整齐,成熟红细胞以小细胞为主,中心淡染区扩大。骨髓细胞外铁染色阴性,铁粒幼红细胞5%。血清铁蛋白10μg/L。试分析该病例。

87、填空题 铁缺乏症包括_____、______、________三期。
88、多项选择题 铁的功能包括()
A.储存铁
B.合成血红蛋白
C.合成肌红蛋白
D.合成含铁酶
E.参与重要代谢
89、配伍题 缺铁性贫血()吸收障碍()珠蛋白生成障碍性贫血()蚕豆病()钩虫病()
A.大细胞正色素性贫血
B.小细胞低色素性贫血
C.红细胞酶缺陷性贫血
D.正常细胞正色素性贫血
E.巨幼细胞性贫血
90、单项选择题 男性,20岁,头昏乏力1年余,经检查确诊为继发性再生障碍性贫血。下列哪项不是引起继发性再障的病因()
A.丙酮酸激酶缺乏
B.电离辐射
C.抗肿瘤药物
D.病毒感染
E.氯霉素
91、单项选择题 男性,2岁,近期发现贫血。体检:中度贫血貌,脾肋下3cm。实验室检查:Hb80g/L,MCV65fl,网织红细胞10%。红细胞渗透脆性降低。其母有贫血史。根据上述情况,推测其血红蛋白电泳的检查结果最可能是下列哪一组()
A.HbA为零或存在,HbF20%~80%,HbA量可减低、正常或增高
B.HbA为零或存在,HbA220%~95%
C.HbA97%,HbA2<3.2%,HbF<1%
D.HbA2>3.2%,HbF1%~6%,其余为HbA
E.HbF20%~95%
92、填空题 常成人主要有____、_____和______三种血红蛋白。
93、多项选择题 PNH与再生障碍性贫血的鉴别在于()
A.前者酸溶血试验阴性
B.前者蛇毒溶血试验阳性
C.前者红细胞渗透脆性试验阳性
D.前者蔗糖溶血试验阳性
E.前者网织红细胞减低
94、填空题 再障的骨髓铁染色可见细胞内、外铁____,血清铁____,血清可溶性转铁蛋白受体____,中性粒细胞碱性磷酸酶活性____。
95、多项选择题 符合溶血性贫血骨髓象特征的是()
A.骨髓增生明显活跃
B.小细胞低色素性贫血
C.粒/红比值减低
D.红细胞系统增生显著
E.可见豪-周小体和卡-波环等红细胞异常结构
96、问答题 试述阵发性睡眠性血红蛋白尿症(PNH)和再生障碍性贫血实验室检查的不同点?
97、多项选择题 溶血性贫血时外周血中常可见()
A.点彩红细胞
B.红细胞缗钱状形成
C.网织红细胞
D.红细胞寿命缩短
E.有核红细胞
98、填空题 ________是导致成人铁缺乏最常见的原因。
99、填空题 红细胞膜缺陷的检验包括____、_____、____和_____等。
100、单项选择题
关于图中所示的红细胞结构,下列说法不正确的()

A.该异常结构为核残余物
B.可能是胞质中的脂蛋白变性所致
C.常与染色质小体同时存在
D.常见于巨幼细胞性贫血患者
E.铅中毒患者也可见这种红细胞结构
101、填空题 临床最常用____和____的测定值来确定有无贫血。
102、多项选择题 与慢性系统性疾病贫血相符的是()
A.正细胞正色素性
B.小细胞低色素性
C.血清铁、运铁蛋白饱和度增加
D.骨髓铁染色细胞外铁减少
E.总铁结合力正常或降低
103、问答题
患者,男,26岁。面色苍白反复发作,伴巩膜黄染,阵发性头晕,气短近5年。每次发作前4~5天均伴有尿色深黄。实验室检查:RBC1.85×1012/L,Hb52g/L,WBC2.6×109/L,血小板60×109/L,网织红细胞35%,尿常规,蛋白(+),RBC1~3个/HP,Rous试验(++),尿胆原(+),胆红素(-),Coombs试验(-)。骨髓象:红系增生活跃,中幼红细胞占29%,晚幼红细胞占22%,成熟红细胞大小不一,中央淡染区稍扩大。试分析该病例。
104、问答题 红细胞膜的功能有哪些?
105、单项选择题 原位溶血的场所主要发生在()
A.肝脏
B.脾脏
C.骨髓
D.肾
E.淋巴结
106、多项选择题 下列哪些符合阵发性冷性血红蛋白尿()
A.儿童多见,无遗传因素
B.与病毒感染有关
C.引起本病的抗体为D-L冷抗体
D.冷热溶血试验阳性
E.Coombs试验阳性
107、单项选择题 下列哪项不符合G-6-PD缺乏症的实验室检查()
A.高铁血红蛋白还原试验还原率下降
B.红细胞组织化学洗脱试验空影细胞大于30%
C.抗人球蛋白试验阳性
D.自溶试验轻度增加,并能被葡萄糖纠正
E.氰化物-抗坏血酸试验阳性
108、配伍题 红细胞膜异常的指标是()免疫性溶血的指标是()提示慢性血管内溶血的是()
A.网织红细胞增多
B.渗透脆性增加
C.Coombs试验阳性
D.热变性试验
E.Rous试验阳性
109、问答题 简述再生障碍性贫血的骨髓病理学特点。
110、填空题 遗传性球形红细胞增多症最常见的临床表现是_____、____和_____。
111、单项选择题
女性27岁,头晕乏力2年,近3个月加重。检验:血红蛋白56g/L,骨髓亚铁氰化钾染色骨髓小粒含铁血黄素(+++)。
进一步检查显示,幼红细胞内铁粒明显增多,环形铁粒幼细胞占25%,则可能为()
A.缺铁性贫血
B.铁粒幼细胞性贫血
C.慢性溶血性贫血
D.珠蛋白合成障碍性贫血
E.巨幼细胞性贫血
112、单项选择题 珠蛋白肽链的分子结构由基因决定,组成“β基因簇”的是()
A.α、β、γ
B.β、γ、δ、ε
C.β、γ、δ、ζ
D.β、γ、δ
E.β、γ、δ、ε、ζ
113、单项选择题 下列哪组符合巨幼细胞性贫血()
A.MCV增高,MCH增高,MCHC减低
B.MCV增高,MCH增高,MCHC正常
C.MCV减低,MCH减低,MCHC正常
D.MCV减低,MCH减低,MCHC减低
E.MCV减低,MCH减低,MCHC增高
114、单项选择题 下列哪项不符合异丙醇试验()
A.试剂pH为7.2
B.异丙醇浓度为17%
C.血红蛋白液应新鲜
D.每次试验应做正常对照
E.正常人呈阴性
115、问答题 诊断红细胞膜缺陷及酶缺陷的检验方法有何不同之处?
116、填空题 急性再障与慢性再障相比,血红蛋白下降____,网织红细胞、白细胞与中性粒细胞和血小板数常____。
117、单项选择题 某男,17岁,头昏乏力,牙龈出血半年。体检:贫血貌,皮肤可见散在瘀点,肝、脾、淋巴结不肿大。疑为再生障碍性贫血。下列哪项最有助于该病的诊断()
A.周围全血细胞减少
B.网织红细胞计数减低
C.正常细胞正常色素性贫血
D.骨髓细胞培养集落生长能力降低
E.骨髓增生低下,造血细胞减少,非造血细胞增多
118、单项选择题 诊断慢性血管内溶血最有意义的阳性结果是()
A.尿胆原阳性
B.黄疸
C.血清间接胆红素阳性
D.抗人球蛋白试验阳性
E.尿含铁血黄素试验阳性
119、单项选择题
女性28岁,头晕乏力、面色苍白2年余。检验:红细胞2.6×10/L,血红蛋白60g/L,MCV,MCH,MCHC均低于正常;血涂片如图。最不可能是哪项贫血()
A.溶血性贫血
B.再生障碍性贫血
C.缺铁性贫血
D.铁粒幼细胞性贫血
E.慢性感染性贫血
120、多项选择题 红细胞膜的功能有()
A.细胞运输
B.信息传递
C.血型抗原
D.凝血调节
E.免疫反应、免疫调节
121、单项选择题 下列哪种试验用于阵发性冷性血红蛋白尿的诊断()
A.高渗冷溶血试验
B.蔗糖溶血试验
C.冷热溶血试验
D.酸溶血试验
E.冷凝集素试验
122、单项选择题 外周血中出现巨大原始红细胞的疾病是()
A.骨髓纤维化
B.恶性肿瘤骨髓转移
C.红白血病
D.再生障碍危象
E.再生障碍性贫血
123、问答题
如何利用红细胞三个平均指数进行贫血形态学分类?
124、单项选择题
该图所示可能为哪种疾病的骨髓象()

A.地中海贫血
B.缺铁性贫血
C.巨幼细胞贫血
D.再生障碍性贫血
E.HbS病
125、多项选择题 影响维生素B12吸收和转运的因素有()
A.胃酸、胃蛋白酶分泌减少
B.全胃切除
C.铁缺乏
D.胰蛋白酶缺乏
E.恶性贫血的内因子完全缺乏
126、问答题 简述成人贫血程度分级标准。
127、单项选择题 收缩蛋白α链用限制性胰蛋白酶消化后,经SDS-PAGE分析显示()
A.2个肽段
B.3个肽段
C.4个肽段
D.5个肽段
E.6个肽段
128、多项选择题 目前认为再障的发病机制主要有()
A.免疫机制异常
B.遗传倾向
C.造血干细胞异常
D.造血微环境缺陷
E.物理因素
129、多项选择题 冷凝集素增高的疾病有()
A.淋巴瘤
B.支原体肺炎
C.疟疾
D.冷凝集素综合征
E.流行性感冒
130、问答题 MDS与再障的血象和骨髓象有何区别?
131、填空题 红细胞的主要能源物质是______,其分解代谢为_____和______两个途径。
132、单项选择题 珠蛋白生成障碍性贫血最常见下列哪种异常形态红细胞增多()
A.破碎红细胞
B.靶形红细胞
C.球形红细胞
D.泪滴形红细胞
E.镰形红细胞
133、多项选择题 正常成人红细胞内没有()
A.HbA
B.HbH
C.HbS
D.HbA2
E.HbF
134、填空题 根据病因不同免疫性溶血性贫血可分为三类:_____、______和______。
135、单项选择题
早期缺铁性贫血多为()

A.正细胞正色素性贫血
B.小细胞正色素性贫血
C.小细胞低色素性贫血
D.大细胞低色素性贫血
E.大细胞性贫血
136、单项选择题 溶血性贫血患者溶血发作期的外周血网织红细饱计数一般为()
A.0.5%~1.5%
B.1.6%~2.5%
C.2.6%~3.5%
D.3.6%~4.5%
E.5.0%~20.0%
137、填空题 Hb的功能主要是运输____和____。
138、多项选择题 铁缺乏症包括()
A.贮存铁缺乏
B.组织铁沉着症
C.缺铁性红细胞生成
D.缺铁性贫血
E.先天性运铁蛋白缺乏症
139、单项选择题
图中所示为一异常形态红细胞,下列说法错误的是()

A.这种异常形态红细胞也称为网球拍样红细胞
B.骨髓纤维化时这种红细胞增多
C.珠蛋白生成障碍性贫血时这种细胞通常不可见
D.骨髓癌转移时可见这种异常红细胞
E.这种细胞形态也可能是推片造成的
140、判断题 出生10天内新生儿Hb小于145g/L诊断为贫血。()
141、多项选择题 下列哪些叙述符合G-6-PD缺乏症()
A.G-6-PD缺乏的黑人有电泳B型酶
B.G-6-PD缺乏是X性连锁隐性或不完全显性遗传
C.A型G-6-PD是一种快速移动电泳变异型,大约见于30%的白人中
D.B型G-6-PD是此酶的正常形式,约见于70%的黄种人和几乎所有黑人
E.红细胞G-6-PD活性测定是这种疾病的确诊试验之一
142、多项选择题 诊断溶血性疾病的必需条件是()
A.红细胞寿命缩短,破坏增加
B.贫血
C.网织红细胞增多
D.Ham试验阳性
E.Coombs试验阳性
143、填空题 正常细胞性贫血首选_________检查。
144、名词解释 干抽
145、判断题 慢性失血是妊娠妇女铁缺乏最常见的原因。()
146、填空题 红细胞的主要能源是葡萄糖,其分解代谢包括_____和_____两个途径。
147、单项选择题
红细胞1.4×1012/L,血红蛋白55g/L,白细胞3.1×109/L,血小板65×109/L,网织红细胞0.10%,MCV129f1,MCH36pg,MCHC0.34,该患者最可能的诊断是()
A.缺铁性贫血
B.溶血性贫血
C.骨髓病性贫血
D.巨幼细胞性贫血
E.珠蛋白生成障碍贫血
148、多项选择题 慢性再障多数病例骨髓象变化是()
A.三系造血细胞减少
B.骨髓增生减低
C.中幼红细胞和巨核细胞减少明显
D.非造血细胞比例增加,常>50%
E.可见“炭核”样晚幼红细胞
149、填空题 铁主要以_____和_______的形式贮存在骨髓等多种细胞和血浆内。
150、填空题 红细胞膜结构的两个最基本的特征是膜的______和_______。
151、单项选择题 诊断温抗体型溶血性贫血最重要的实验室检查是()
A.Ham试验
B.Donath-Landsteiner试验
C.免疫球蛋白测定
D.Coombs试验
E.血红蛋白电泳
152、单项选择题 下列哪项符合小细胞低色素性贫血()
A.MCV55fl,MCH21pg,MCHC0.29
B.MCV82fl,MCH29pg,MCHC0.34
C.MCV105fl,MCH36pg,MCHC0.41
D.MCV71fl,MCH25pg,MCHC0.34
E.MCV100fl,MCH33pg,MCHC0.38
153、多项选择题
如图所示的异常红细胞结构可见于下列哪些疾病()

A.溶血性贫血
B.巨幼红细胞性贫血
C.脾切除术后
D.铅中毒
E.缺铁性贫血
154、单项选择题 红细胞渗透脆性试验脆性增加主要见于()
A.PNH
B.海洋性贫血
C.遗传性球形红细胞增多症
D.再生障碍性贫血
E.自身免疫性溶血性贫血
155、问答题
试述血管内溶血和血管外溶血的鉴别。
156、单项选择题 红细胞膜结构的两个最基本特征是()
A.韧性和对称性
B.粘性和对称性
C.流动性和对称性
D.粘性和不对称性
E.流动性和不对称性
157、单项选择题 血红蛋白减少较红细胞减少明显的贫血是()
A.再生障碍性贫血
B.急性溶血性贫血
C.缺铁性贫血
D.巨幼细胞性贫血
E.铁粒幼细胞贫血
158、多项选择题 下列哪些检验结果符合缺铁性贫血()
A.铁降低
B.铁饱和度降低
C.铁蛋白降低
D.转铁蛋白升高
E.总铁结合力降低
159、填空题 铁染色有助于鉴别____________和_____________这两种小细胞低色素性贫血。
160、填空题 红细胞膜骨架系统对维持红细胞的____、____和___起重要作用。
161、多项选择题 溶血性贫血时红细胞中常可见()
A.Howell-Jolly小体
B.棒状小体
C.卡-波环
D.中毒颗粒
E.球形包涵体
162、单项选择题 外周血反映骨髓幼红细胞增生程度的准确指标是()
A.网织红细胞百分比
B.网织红细胞绝对值
C.红细胞计数
D.周围血出现有核红细胞
E.红细胞内出现豪周小体
163、多项选择题 下列哪些因素不会使红细胞变形性下降()
A.红细胞膜蛋白异常
B.形成变性珠蛋白小体
C.维生素B12缺乏
D.红细胞膜磷脂减少
E.铁离子缺乏
164、问答题 正常成人血红蛋白有哪几种?
165、单项选择题 具有保护Hb的巯基及RBC膜作用的RBC酶为()
A.G-6-PD酶
B.丙酮酸脱氢酶
C.乳酸脱氢酶
D.铁血红蛋白还原酶
E.谷胱甘肽还原酶
166、单项选择题 人体缺铁时,最早表现的是()
A.FEP增高
B.血清铁降低
C.血清铁蛋白降低
D.血清总铁结合力增高
E.转铁蛋白饱和度降低
167、名词解释 不稳定血红蛋白病
168、多项选择题
图中所示的异常红细胞可见于哪些疾病()
A.遗传性椭圆性红细胞增多症
B.缺铁性贫血
C.恶性贫血
D.地中海贫血
E.HbS病
169、多项选择题 下述表现属于血管外溶血的是()
A.脾肿大
B.尿含铁血黄素阳性
C.网织红细胞增高
D.遗传性多见
E.常见红细胞形态改变
170、填空题 _____和________是引起继发性红细胞增多的主要原因。
171、单项选择题 女性,48岁,诊断缺铁性贫血。给予铁剂治疗后Hb上升至130g/L。为保证机体有足够的储存铁,需继续铁剂治疗。期间需选择下列哪项指标监测体内储存铁的变化()
A.血清铁
B.铁蛋白
C.转铁蛋白
D.可溶性转铁蛋白受体
E.总铁结合力
172、多项选择题
某贫血患者的血涂片、骨髓涂片、PAS染色分别如图所示,下列说法正确的是()
A.该患者为大细胞正色素性贫血
B.MCV升高,MCH升高,MCHC正常,RDW升高
C.这类贫血患者血涂片上可见点彩红细胞、H-J小体及有核红细胞
D.细胞内外铁均增高
E.白细胞数正常或减低
173、单项选择题 人红细胞膜脂质包括()
A.糖脂
B.胆固醇和中性脂肪
C.甘油磷脂
D.鞘磷脂
E.以上全部
174、单项选择题 正常成人每天铁利用量一般为()
A.11mg左右
B.22mg左右
C.33mg左右
D.44mg左右
E.55mg左右
175、单项选择题
男性,36岁,头晕乏力1年余,近1个月加重伴皮肤黄染。检验:血红蛋白50g/L,白细胞3.0×109/L,血小板48×109/L,网织红细胞20%;尿胆红素(-),尿胆原(+),尿含铁血黄素(+),血清铁蛋白12μg/L;骨髓检查示增生活跃,红系占53%,以中幼、晚幼红细胞增生为主。
再次询问病史时,下列哪项最为重要()
A.有无服用药物史
B.有无电离辐射史
C.有无消化道出血史
D.有无酱油色尿发作史
E.有无胆石症史
176、判断题 PK缺乏症时加葡萄糖不能纠正,加ATP可纠正。()
177、填空题 根据贫血的病因及发病机制通常可将贫血分为三大类:_____________、_____________、______。
178、判断题 正常血红蛋白HbA裂解后出现β、HbA、HbA2、α四条带。()
179、多项选择题 哪些贫血网织红细胞常明显增加()
A.缺铁性贫血
B.再生障碍危象
C.溶血性贫血
D.失血性贫血
E.巨幼细胞性贫血
180、配伍题 高铁血红蛋白还原试验用于检测()血红蛋白电泳用于检测()红细胞渗透胞性试验用于检测()Coombs试验用于检测()
A.遗传性球形红细胞增多症
B.胎儿水肿综合征
C.蚕豆病
D.PNH
E.阵发性冷性血红蛋白尿症
181、问答题 红细胞计数和血红蛋白测定值变化的病理意义是什么?
182、填空题 根据发病原因,再障可分为____和____,通常所说的再障是指___。
183、判断题 通常所说的再障是指获得性再障。()
184、多项选择题 血管内溶血的特点包括()
A.脾脏不一定肿大
B.血红蛋白尿
C.血红蛋白血症
D.血清结合珠蛋白升高
E.寒战、高热、腰背酸痛
185、单项选择题 男性轻度贫血,其血红蛋白可能为()
A.122g/L
B.98g/L
C.80g/L
D.58g/L
E.30g/L
186、单项选择题 收缩蛋白的β链用限制性胰蛋白酶消化后,经SDS-PAGE分析显示()
A.2个肽段
B.3个肽段
C.4个肽段
D.5个肽段
E.6个肽段
187、名词解释 免疫性溶血性贫血
188、单项选择题 下列疾病与血管内溶血无关的是()
A.自身免疫性溶血性贫血
B.G-6-PD缺乏症
C.疟疾
D.PNH
E.阵发性冷性血红蛋白尿
189、单项选择题
外周血涂片如图,该患者可能为下列何种疾病()

A.口形红细胞增多症
B.遗传性球形红细胞增多症
C.缺铁性贫血
D.再障
E.HbS病
190、单项选择题 再障患者骨髓病理组织学检验发现造血细胞减少,尤其是()
A.巨大原始红细胞
B.巨大早幼粒细胞
C.巨核细胞
D.巨大血小板
E.巨大原始粒细胞
191、填空题 血浆游离血红蛋白明显增高是判断_____的指征,______、______、______、______等疾病血浆游离血红蛋白明显增高。
192、单项选择题 血红素合成场所为()
A.肝细胞高尔基体内
B.有核红细胞的溶酶体内
C.有核红细胞和肝细胞的高尔基体内
D.有核红细胞和肝细胞的线粒体内
E.有核红细胞和肝细胞的溶酶体内
193、问答题 试述骨髓纤维化症与再生障碍性贫血的鉴别诊断。
194、单项选择题 下列说法哪项不符合冷凝集素综合征()
A.抗体为IgM
B.0~4℃时凝集反应最强
C.溶血不需要补体参与
D.可见红细胞呈缗钱状
E.冷溶血试验阴性
195、问答题 HbF酸洗脱试验原理和临床意义是什么?
196、单项选择题 诊断急性血管内溶血最有意义的结果是()
A.黄疸
B.红细胞减少
C.血红蛋白血症和血红蛋白尿
D.尿胆原增加
E.红细胞渗透脆性试验阳性
197、问答题 自身溶血试验及纠正试验有何临床意义?
198、多项选择题
如图所示的异常红细胞增多可见于()
A.α地中海贫血
B.β地中海贫血
C.遗传性球形红细胞增多症
D.温抗体型自身免疫性溶血性贫血
E.PNH
199、判断题 对于小细胞低色素性贫血的诊断应首选有关铁代谢的检验项目。()
200、多项选择题 下列不符合再障临床检验的是()
A.血清铁增高
B.细胞内、外铁减少
C.血清可溶性转铁蛋白受体(sTfR)增高
D.中性粒细胞碱性磷酸酶活性降低
E.贫血为小细胞性
201、问答题 珠蛋白生成障碍性贫血如何分类?
202、单项选择题 诊断缺铁的重要指标之一是()
A.转铁蛋白
B.铁结合力
C.血清铁
D.铁饱和度
E.骨髓可染铁消失
203、填空题
成人贫血的诊断标准为:男性血红蛋白(g/L)____,血细胞比容(HCT)____,红细胞计数(×1012/L)____;女性血红蛋白(g/L)____;血细胞比容(HCT)____,红细胞计数(×1012/L)____。
204、多项选择题 符合遗传性铁粒幼细胞贫血的是()
A.多见于男性,幼年和成年均可发病
B.常有家族史
C.吡哆醇治疗无效
D.遗传形式多为不完全X染色体性连锁隐性遗传,极少数为常染色体隐性遗传
E.大细胞性贫血
205、单项选择题 红细胞膜中含量最多的蛋白是()
A.锚蛋白
B.带3蛋白
C.收缩蛋白
D.4.1蛋白
E.4.2蛋白
206、填空题 G-6-PD缺乏症在临床上分为五种类型:__________________、__________、__________、__________和___________。
207、单项选择题 下列组合中不正确的是()
A.再生障碍性贫血——小细胞低色素性贫血
B.骨髓病性贫血——正细胞正色素性贫血
C.溶血性贫血——正细胞正色素性贫血
D.缺铁性贫血——小细胞低色素性贫血
E.巨幼红细胞性贫血——可见红细胞大小不均
208、单项选择题 下列哪项属于遗传性溶血性贫血()
A.镰状细胞贫血
B.阵发性睡眠性血红蛋白尿症
C.自身免疫性溶血性贫血
D.ABO血型不合溶血性贫血
E.微血管病性溶血性贫血
209、单项选择题
男性,16岁,面色苍白半年。体检:中度贫血貌,巩膜轻度黄染,脾肋下2.5cm。检验:血红蛋白81g/L,白细胞及血小板正常,网织红细胞16%;Coombs试验(-);红细胞渗透脆性试验,初溶为58%氯化钠溶液,全溶为46%氯化钠溶液。
若确诊为上题中的疾病,下列说法正确的是()
A.可分为水肿细胞型、干细胞型和其他型
B.红细胞渗透脆性试验示脆性增加,红细胞寿命缩短
C.自身溶血试验溶血>5%,加ATP不能纠正
D.为常染色体隐性遗传性疾病
E.病变来源于造血干细胞的突变,是一种克隆病
210、单项选择题
女性27岁,头晕乏力2年,近3个月加重。检验:血红蛋白56g/L,骨髓亚铁氰化钾染色骨髓小粒含铁血黄素(+++)。
若该患者骨髓亚铁氰化钾染色骨髓小粒含铁血黄素(+),幼红细胞内铁粒减少,骨髓象显示:中晚幼红细胞45%,体积小,胞质量少,边缘不规则,最有可能为()
A.再生障碍性贫血
B.珠蛋白合成障碍性贫血
C.慢性溶血性贫血
D.缺铁性贫血
E.巨幼细胞性贫血
211、名词解释 血清铁
212、单项选择题 不属于红细胞生成减少性贫血的是()
A.缺铁性贫血
B.红细胞酶缺陷性贫血
C.铁粒幼细胞贫血
D.再生障碍性贫血
E.营养性巨幼细胞性贫血
213、多项选择题 有助于自身免疫性溶血性贫血诊断的试验有()
A.抗人球蛋白试验
B.变性珠蛋白小体生成试验
C.血清内因子阻断抗体试验
D.红细胞包涵体试验
E.冷凝集素试验
214、单项选择题 血红蛋白是由()
A.一对珠蛋白肽链和二个亚铁血红素组成
B.一对珠蛋白肽链和四个亚亚铁血红素组成
C.两对珠蛋白肽链和二个亚铁血红素组成
D.两对珠蛋白肽链和三个亚铁血红素组成
E.两对珠蛋白肽链和四个亚铁血红素组成
215、单项选择题 Heinz小体生成试验与下列哪种疾病有关()
A.PNH
B.PK酶缺乏症
C.遗传性球形红细胞增多症
D.G-6-PD缺乏症
E.自身免疫性溶血性贫血
216、填空题 根据红细胞破坏场所的不同,溶血可分为______和______。
217、填空题 红细胞膜由____、___、___和____等组成。
218、单项选择题 下列哪项不是血红蛋白肽链结构()
A.HbA-αβ
B.HbA-α2β2
C.HbA2-α2δ2
D.HbF-α2γ2
E.HbBarts-γ4
219、多项选择题 下列哪些指标支持再生障碍性贫血的诊断()
A.MCV88fl
B.MCV52fl
C.MCH30pg
D.MCH20pg
E.MCHC0.33
220、单项选择题
男性,16岁,面色苍白半年。体检:中度贫血貌,巩膜轻度黄染,脾肋下2.5cm。检验:血红蛋白81g/L,白细胞及血小板正常,网织红细胞16%;Coombs试验(-);红细胞渗透脆性试验,初溶为58%氯化钠溶液,全溶为46%氯化钠溶液。
下列哪项检查对该病的诊断价值不大()
A.骨髓涂片检查
B.外周血涂片检查
C.红细胞直径测定
D.红细胞厚度测定
E.红细胞渗透脆性试验
221、多项选择题 PNH可并发()
A.巨幼红细胞性贫血
B.再生障碍性贫血
C.缺铁性贫血
D.门静脉血栓
E.DIC
222、单项选择题
男性,38岁,半年前患急性黄疸型肝炎,近半个月来出现发热、牙龈出血。体检:重度贫血貌,肝肋下2cm,脾肋下可及。检验:红细胞1.8×1012/L,血红蛋白55g/L,白细胞2.5×109/L,血小板32×109/L,网织红细胞0.2%
患者最可能为()
A.再生障碍性贫血
B.慢性肝病性贫血
C.脾功能亢进
D.巨幼细胞性贫血
E.恶性组织细胞增生症
223、单项选择题 骨髓涂片细胞形态学检查不能确诊的疾病是()
A.急性白血病
B.再生障碍性贫血
C.多发性骨髓瘤
D.慢性白血病
E.缺铁性贫血
224、单项选择题
女性,29岁,一年来面色苍白,乏力气短。检验:红细胞2.5×1O/L,血红蛋白55g/L,MCV74fl,MCH20pg,MCHC0.30,网织红细胞1.5%,血涂片红细胞淡染区扩大。
下列实验室检查最有诊断意义的是()
A.骨髓内外铁染色
B.血清铁饱和度测定
C.血清铁测定
D.转铁蛋白饱和度
E.血清总铁结合力测定
225、单项选择题 影响DNA合成的常见因素()
A.丙酮酸激酶缺乏
B.铁缺乏
C.叶酸和维生素B12缺乏
D.维生素C缺乏
E.微量元素缺乏
226、单项选择题 下列不是缺铁性贫血原因的是()
A.多次妊娠和哺乳的妇女
B.长期偏食
C.慢性失血
D.药物或毒物的作用
E.发育中的婴儿和青少年
227、多项选择题 红细胞膜的功能包括哪些()
A.维持红细胞的正常形态和变形性
B.参与红细胞内外物质的运输
C.与免疫复合物的清除有关
D.调节补体的活性
E.具有抗原性
228、多项选择题 关于遗传性球形红细胞增多症的描述哪些是正确的()
A.临床上常见静脉血栓形成
B.是最常见的遗传性红细胞膜缺陷所致的溶血
C.外周血小球形红细胞大于10%
D.渗透脆性增加:于5.2~7.2g/L的低渗盐水开始溶解,4.0g/L完全溶解
E.应与自身免疫性溶血性贫血所致继发性球形细胞增多症相鉴别
229、配伍题 血红蛋白电泳用于检测()高铁血红蛋白还原试验用于检测()Coombs试验用于检测()Ham试验用于检测()
A.珠蛋白生成障碍性贫血
B.遗传性球形红细胞增多症
C.PNH
D.G-6-PD缺乏症
E.自身免疫性溶血性贫血
230、问答题 简述G-6-PD酶缺乏症溶血机制。
231、多项选择题 下列疾病中,属于增生性贫血的是()
A.缺铁性贫血
B.巨幼细胞性贫血
C.溶血性贫血
D.再生障碍性贫血
E.失血性贫血
232、单项选择题 关于红细胞膜稳定性下面哪项说法不对()
A.氧化损伤不影响膜稳定性
B.细菌毒素影响膜稳定性
C.酶代谢异常影响膜稳定性
D.自身抗体与红细胞结合影响膜稳定性
E.红细胞膜蛋白遗传性缺陷影响膜稳定性
233、名词解释 纯红细胞再生障碍性贫血
234、名词解释 血管内溶血
235、单项选择题
男性,36岁,头晕乏力1年余,近1个月加重伴皮肤黄染。检验:血红蛋白50g/L,白细胞3.0×109/L,血小板48×109/L,网织红细胞20%;尿胆红素(-),尿胆原(+),尿含铁血黄素(+),血清铁蛋白12μg/L;骨髓检查示增生活跃,红系占53%,以中幼、晚幼红细胞增生为主。
下列哪项检查最具确诊意义()
A.骨髓铁染色
B.糖水试验
C.Ham试验
D.Coombs试验
E.血清游离血红蛋白测定
236、配伍题 血清铁降低,骨髓细胞外铁增高,内铁减少()骨髓铁染色见细胞内外铁均增加()血清铁降低,总铁结合力增高()血清铁增高,sTfR减少()
A.再生障碍性贫血
B.慢性感染性贫血
C.溶血性贫血
D.缺铁性贫血
E.遗传性球形红细胞增多症
237、问答题 试述自身免疫性溶血性贫血的实验室诊断步骤。
238、判断题 人体内血红蛋白铁是最活跃的部分。()
239、问答题 抗人球蛋白试验的原理是什么?
240、名词解释 双相性贫血
241、多项选择题 下列哪几项可作为确诊溶血的证据()
A.直接胆红素增高
B.血浆高铁血红素白蛋白阳性
C.尿胆原阴性
D.血浆游离血红蛋白增高
E.血清结合珠蛋白减低
242、多项选择题 关于总铁结合力和转铁蛋白的关系,下列说法错误的是()
A.总铁结合力反映的是血清铁蛋白的水平
B.总铁结合力反映的是血清转铁蛋白的水平
C.总铁结合力等于血清可溶性转铁蛋白受体的水平
D.总铁结合力与血清铁蛋白成正比关系
E.总铁结合力反映的是血清转铁蛋白饱和度的水平
243、单项选择题 下列哪种疾病可能出现单纯小细胞性贫血()
A.珠蛋白生成障碍性贫血
B.缺铁性贫血
C.巨幼细胞性贫血
D.白血病
E.尿毒症
244、单项选择题 下列哪项不是溶血性贫血的特征()
A.周围血网织红细胞计数增高
B.红细胞、血红蛋白减少
C.血清间接胆红素增高
D.髓有核红细胞增生活跃
E.尿胆红素阳性
245、单项选择题 MCV 109fl,MCH 37pg,MCHC 0.34,其贫血属于()
A.单纯小细胞性贫血
B.小细胞低色素性贫血
C.正常细胞性贫血
D.大细胞性贫血
E.巨幼细胞性贫血
246、多项选择题 对于增生性贫血,下列说法正确的是()
A.骨髓增生明显活跃
B.周围血网织红细胞增多
C.周围血涂片红细胞大小不均
D.周围血出现有核红细胞
E.白细胞总数增加
247、单项选择题 下列疾病中可溶性转铁蛋白受体不增加的是()
A.缺铁性贫血
B.无效生成性贫血
C.溶血性贫血
D.巨幼细胞贫血
E.再生障碍性贫血
248、单项选择题 下列哪项属于血管内溶血()
A.PNH
B.缺铁性贫血
C.脾功能亢进
D.β珠蛋白生成障碍性贫血
E.丙酮酸激酶缺乏症
249、多项选择题 关于溶血性贫血下列哪些是正确的()
A.血清间接胆红素增加
B.尿胆原增高
C.血涂片可见幼稚红细胞
D.血清结合珠蛋白增加
E.骨髓红细胞系统增生
250、多项选择题 下列属于造血功能障碍所致的贫血是()
A.再生障碍性贫血
B.白血病
C.骨髓病性贫血
D.骨髓增生异常综合征
E.恶性贫血
251、多项选择题
如图所示的异常红细胞结构常见于下列哪些疾病()
A.蚕豆病
B.巨幼红细胞性贫血
C.溶血性贫血
D.红白血病
E.再生障碍性贫血
252、单项选择题
男性,57岁,近半个月厌食、恶心、头晕、乏力伴皮肤黄染。检验:血红蛋白80g/L,网织红细胞5%;红细胞脆性试验轻度增加;尿胆红素阴性,尿胆原强阳性,尿潜血检查阴性,血清总胆红素77.25μmol/L,ALT28U/L。拟诊为溶血性贫血。
若患者出现酱油色尿,高铁血红蛋白还原试验及荧光斑点试验(+),可能的诊断是()
A.珠蛋白生成障碍性贫血
B.G-6-PD缺乏症
C.稳定血红蛋白病
D.PK酶缺乏症
E.PNH
253、单项选择题
女性27岁,头晕乏力2年,近3个月加重。检验:血红蛋白56g/L,骨髓亚铁氰化钾染色骨髓小粒含铁血黄素(+++)。
最不可能为()
A.慢性再生障碍性贫血
B.巨幼细胞性贫血
C.慢性感染性贫血
D.慢性溶血性贫血
E.缺铁性贫血
254、单项选择题 关于RBCMCV的叙述,下列哪项正确()
A.MCV正常,提示患者RBC形态无改变
B.MCV、MCH、MCHC三者之间无联系
C.MCV小于正常,MCH小于正常,其MCHC必小于正常
D.MCV大于正常,MCH大于正常,其MCHC必大于正常
E.贫血患者MCV可在正常范围内
255、单项选择题 诊断温抗体型自身免疫性溶血性贫血最重要的实验室检查是()
A.Ham试验
B.免疫球蛋白试验
C.血红蛋白电泳
D.游离血红蛋白测定
E.Coombs试验
256、单项选择题 我国最常见的血红蛋白病是()
A.HbC病
B.HbD病
C.HbE病
D.HbS病
E.稳定Hb病
257、填空题 再障危象骨髓涂片中可见________是其突出特点。
258、单项选择题
某家族性遗传病患者血涂片如图,红细胞渗透脆性增加,下述哪项不符合其病情。()
A.脾肿大
B.红细胞在脾窦被破坏
C.血红蛋白电泳出现异常区带
D.尿胆原阳性
E.网织红细胞明显增高
259、单项选择题 符合缺铁性贫血的实验室检查是()
A.血清铁蛋白降低,总铁结合力降低
B.血清铁蛋白正常,总铁结合力降低
C.血清铁蛋白降低,总铁结合力降低
D.血清铁蛋白降低,总铁结合力正常
E.血清铁蛋白降低,总铁结合力增高
260、名词解释 丙酮酸激酶缺乏症
261、单项选择题 育龄妇女每天平均约排出铁量()
A.1mg
B.2mg
C.3mg
D.4mg
E.5mg
262、多项选择题
某患者血涂片和骨髓涂片分别见图,该患者可能为()

A.巨幼细胞贫血
B.再障
C.缺铁性贫血
D.慢性失血
E.急性失血
263、单项选择题
女性,29岁,一年来面色苍白,乏力气短。检验:红细胞2.5×1O/L,血红蛋白55g/L,MCV74fl,MCH20pg,MCHC0.30,网织红细胞1.5%,血涂片红细胞淡染区扩大。
初步诊断最可能为()
A.再障
B.遗传性球形红细胞增多症
C.白血病
D.缺铁性贫血
E.巨幼细胞贫血
264、填空题 成人贫血程度划为________级。
265、配伍题 先天性球形红细胞增多症()G-6-PD酶缺陷性溶血性贫血()PK酶缺陷性溶血性贫血()
A.自身溶血轻度增强,加葡萄糖轻度纠正
B.自身溶血明显增强,加葡萄糖不能纠正
C.自身溶血减低,加葡萄糖不能纠正
D.自身溶血减低,加葡萄糖明显纠正
E.自身溶血试验明显增强,加葡萄糖明显纠正
266、填空题 G-6-PD是红细胞糖代谢___________途径的关键酶;PK酶是红细胞内_______途径的重要酶。
267、判断题 6个月以上小儿贫血程度的划分同成人标准。()
268、填空题 _______是红细胞膜中含量最多的一种跨膜糖蛋白。
269、单项选择题 诊断缺铁性贫血敏感可靠的实验的是()
A.血清铁蛋白测定
B.体格检查
C.血清铁测定
D.CT扫描
E.骨髓检查
270、单项选择题 下述哪项疾病不是血管外溶血()
A.阵发性冷性血红蛋白尿症
B.丙酮酸激酶缺陷症
C.先天性球形红细胞增多症
D.微血管病性溶血性贫血
E.不稳定血红蛋白病
271、单项选择题 HbBarts见于下列哪种疾病()
A.HbC病
B.α珠蛋白生成障碍性贫血
C.β珠蛋白生成障碍性贫血
D.HbS病
E.HbE病
272、单项选择题 原发性再生障碍性贫血骨髓象检查不可能出现的改变是()
A.骨髓增生活跃
B.巨核细胞减少
C.粒红比例降低
D.粒细胞系统成熟停滞于早期阶段
E.浆细胞、组织嗜碱细胞及网状细胞增多
273、填空题 根据病因分类巨幼细胞贫血可分为_____、______________、_____________________的巨幼细胞贫血。
274、多项选择题 下列哪些可作为PNH与再生障碍性贫血的鉴别()
A.酸溶血
B.蔗糖溶血
C.骨髓增生情况
D.中性粒细胞碱性磷酸酶染色
E.有无黄疸、血红蛋白尿
275、判断题 真性红细胞增多症患者骨髓红细胞系、粒细胞系和巨核细胞系均有异常增生。()
276、单项选择题
图中所示红细胞异常结构为()
A.H-J小体
B.杜勒小体
C.嗜碱性点彩红细胞
D.疟原虫
E.网织红细胞
277、多项选择题 外周血涂片观察成熟红细胞形态对下列哪些疾病有诊断意义()
A.遗传性球形红细胞增多症
B.遗传性椭圆形红细胞增多症
C.再生障碍性贫血
D.珠蛋白生成障碍性贫血
E.G-6-PD缺乏症
278、多项选择题 下列哪些不是急性再障的血象表现()
A.正常细胞性贫血
B.网织红细胞>2%
C.血红蛋白下降缓慢
D.血小板<10×109/L
E.中性粒细胞<0.5×109/L
279、单项选择题
图中所示的红细胞结构为()

A.杜勒小体
B.嗜碱性点彩红细胞
C.H-J小体
D.有核红细胞
E.疟原虫
280、多项选择题 下列哪些试验对不稳定血红蛋白病具有诊断价值()
A.热变性试验
B.变性珠蛋白小体试验
C.肽链分析试验
D.酸溶血试验
E.异丙醇试验
281、单项选择题 下列哪项符合再生障碍性贫血()
A.RDW正常,MCV正常
B.RDW正常,MCV增高
C.RDW正常,MCV减低
D.RDW增高,MCV正常
E.RDW增高,MCV增高
282、问答题 简述成人贫血程度分级标准。
283、单项选择题
患者,女,31岁,2年前无明显诱因出现巩膜发黄,全身乏力,常感头昏,皮肤瘙痒,并多次出现酱油色尿。近两个月来,乏力加重,无法正常工作而入院治疗。体格检查:中度贫血貌,巩膜黄染,肝肋下2cm,脾平脐,其余未见异常。血常规:WBC9.2×10/L,Hb42g/L,RBC1.08×10/L,PLT109×10/L。外周血可见晚幼红细胞及晚幼粒细胞,成熟红细胞明显大小不等和形态异常,可见较多的小球形红细胞和嗜多色性红细胞,网织红细胞32%。拟诊“溶血性贫血”入院。
为进一步明确溶血的存在,应首选哪项实验室检查()
A.肝功能测定
B.肾功能测定
C.补体测定
D.红细胞沉降率测定
E.LDH、总胆红素、间接胆红素、血红蛋白尿等测定
284、单项选择题 DNA合成过程中的重要辅酶是()
A.叶酸还原酶
B.TPH
C.二氢叶酸还原酶
D.5-甲酰四氢叶酸
E.NADPH
285、问答题 如何确定溶血性贫血的病因?
286、单项选择题
女性,29岁,一年来面色苍白,乏力气短。检验:红细胞2.5×1O/L,血红蛋白55g/L,MCV74fl,MCH20pg,MCHC0.30,网织红细胞1.5%,血涂片红细胞淡染区扩大。
进行血清铁代谢检查,有可能出现()
A.血清铁减少,总铁结合力减少
B.血清铁减少,血清铁饱和度增加
C.血清铁减少,血清铁蛋白增加
D.清铁减少,红细胞内游离原卟啉减少
E.血清铁减少,总铁结合力增加
287、问答题 简述缺铁性贫血红细胞生成的诊断标准。
288、填空题 继发性再障的病因主要有:____________、___________、____________、_____________。
289、问答题 缺铁性贫血的铁代谢检测指标有什么变化?
290、填空题 贫血的诊断过程为:___;_____;_____;_______。
291、名词解释 细胞外铁
292、多项选择题 血管外溶血的特点不包括()
A.脾肿大
B.血红蛋白血症
C.血浆结合珠蛋白升高
D.贫血、黄疸
E.血红蛋白尿
293、单项选择题 下列哪种疾病的血象、骨髓象中血小板、巨核细胞均减少()
A.脾功能亢进
B.Evan综合征
C.再生障碍性贫血
D.特发性血小板减少性紫癜
E.巨幼细胞性贫血
294、多项选择题 重型β珠蛋白生成障碍性贫血的Hb电泳结果是()
A.HbA增加
B.HbH出现
C.HbF增加
D.HbA可增加,或降低,或正常
E.HbA明显减少或消失
295、名词解释 急性造血功能停滞
296、填空题 再障所引起的贫血类型多数为________,少数为______。
297、单项选择题 不属于遗传性红细胞内在缺陷的是()
A.G-6-PD缺乏症
B.异常Hb病
C.PK缺乏症
D.巨幼细胞贫血
E.遗传性球形红细胞增多症
298、单项选择题 红细胞膜蛋白的遗传性缺陷常见于()
A.收缩蛋白
B.带3蛋白
C.4.1蛋白
D.锚蛋白
E.以上全部
299、问答题 哪些实验室检查结果可以显示有溶血性贫血的可能性?
300、多项选择题 临床上同时存在贫血及脾肿大的疾病是()
A.缺铁性贫血
B.再生障碍性贫血
C.巨幼红细胞性贫血
D.先天性球形红细胞增多症
E.G-6-PD缺乏症